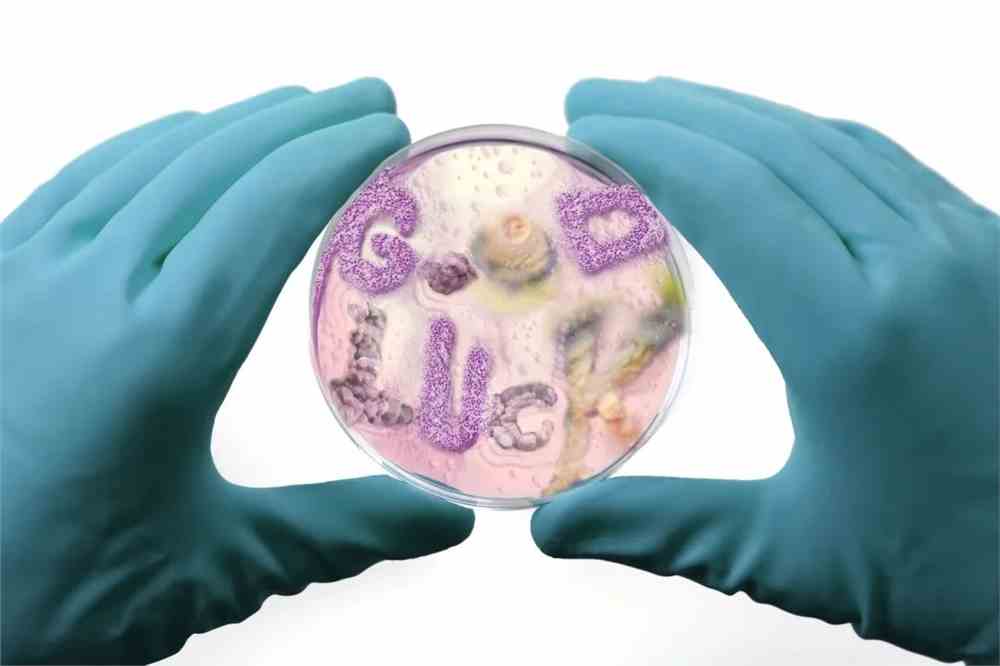
2021世界插画大赛WIA获奖作品出炉!各国画师风格迥异 世界插画大赛
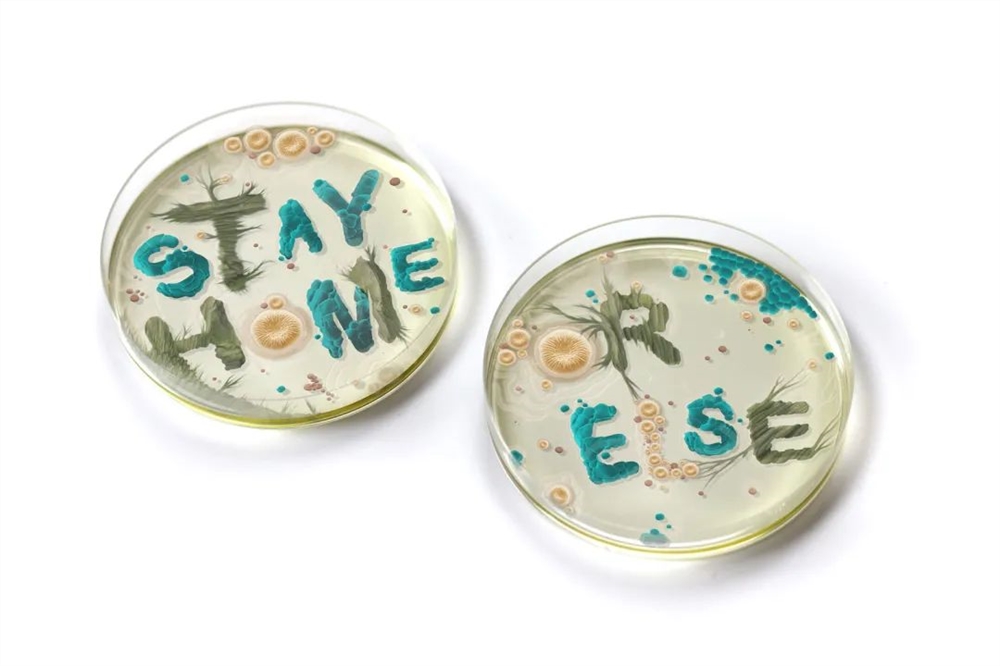
2021世界插画大赛WIA获奖作品出炉!各国画师风格迥异 世界插画大赛
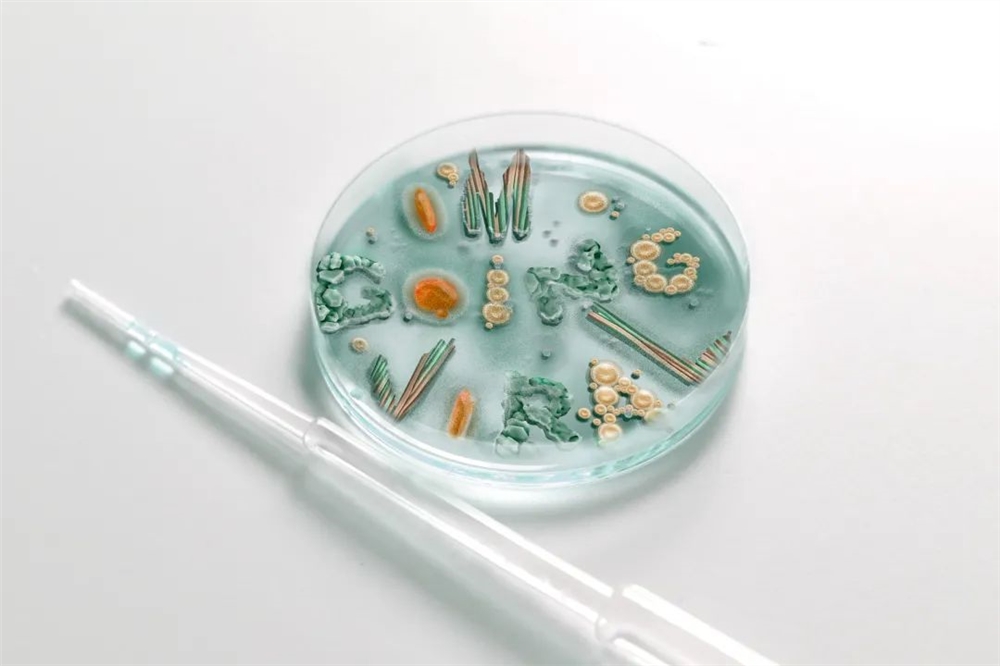
2021世界插画大赛WIA获奖作品出炉!各国画师风格迥异 世界插画大赛

最近,期待已久的世界插画大奖
World Illustration Awards
公布了2021年获奖的长名单
获奖作品来自82个国家的插画师
投稿的5280件作品,包括2个全场大奖
10个组别优胜奖、
10组推荐奖、4个跨类别奖

世界插画大赛WIA是世界范围内公认
最综合最重要最具影响力的插画大赛之一
由全球历史最悠久的插画行业组织
英国插画协会及全球最具影响力的插画
展示平台美国《插画目录》联合主办
大赛包含了10大参赛类别,包含广告、出版
商业插画、儿童插画、
产品及包装、科技、特定项目等
延续45年的全球性插画赛事,覆盖国家最多
是代表着国际插画最高水准的大赛之一

本期就来和大家分享
2021WIA世界插画大赛获奖作品
看看哪一幅是你的“全场最佳”!
1
全场大奖
专业组 / 编辑类插画
The Other US Epidemic
Fatinha Ramos

作者通过离去的人和留下的人这两个角度来表现“自杀”行为的情感部分,希望这幅作品能引起人们的情感共鸣,给予慰藉。
新锐组 / 产品设计及包装
Cabinet of Curiosities
Dani Choi

该作品是作者为一家位于曼哈顿的韩国餐厅绘制的12幅菜单插图,并作为礼物送给每一位顾客。充满韩国文化元素的图像,让顾客留下深刻的用餐体验。
2
组别优胜奖
类目一:广告
Minari Movie Postcards
Sojung Kim-McCarthy / 专业组



作者为金球奖最佳外语电影《Minari》制作的宣传海报,电影讲述了一个美籍韩裔家庭的移民生活。海报充满了浓浓的复古美式风,让观众感受到80年代的美洲风情。
[more]
Marie Doerfler/新锐组





类目二:另类读物
From London, Heading South: A Zine
Amy Moss/专业组





插画记录了作者与友人的一次难忘的海岸旅行,那是她人生中最美好的一段回忆。
Living with Endometriosis
Justyna Green/新锐组


作者以插画的形式记录下她在疾病治疗过程中的认识和体会,希望能引起有同样症状的女性的注意,以此提高对疾病治疗的认识。
类目三:书籍封面
I Know Why the Caged Bird Sings
Shabazz Larkin/专业组

The Night Manager
Ioana Bolchis/新锐组

类目四:儿童出版物
I am the Subway
Kim Hyo-Eun/专业组




Mai
Dide Tengiz/新锐组




巨人就是我们的“地球母亲”,她身形高大却意外的脆弱,需要大家的珍惜和爱护。
类目五:商业出版
The Book of Trespass
Nick Hayes/专业组




Cain and Abel
Katie Bullimore/新锐组




插画灵感来源于圣经,作者尤其喜欢旧约中黑暗的哥特式故事,想以图像的方式更直观地传达原作故事的气氛。
类目六:产品设计及包装
New World poster series
Zamo Peza/专业组





Cabinet of Curiosities
Dani Choi/新锐组

类目七:编辑类插画
Collection
Jialei Sun/新锐组





作者几乎一整年都呆在家里,发现自己花在购物上的时间少很多。生活中没有添加新东西的感觉让她想做一些作品来满足购物欲望。所以她把她想买的东西组合在一起,然后放进插图里。
类目八:探索
Morphing Shadow
Maryam Khaleghiyazdi/专业组

Portraits of Westlake
Dominic Bodden/新锐组




这一系列插图调查了中产阶级化对洛杉矶西湖社区的影响,以及当地家庭和企业如何适应社区的许多变化。当人们试图生存时,重点是传统和创新的交叉方式。
类目九:科技
Earth's Processes
Victoria Nakada/专业组



作者创作这些插图是为了以一种更程式化的方式来表现科学过程,而不仅仅是为了提供信息。这些发生在我们周围的过程对地球来说是自然的,但我们从中受益匪浅。想把它们作为对地球的一个简单的“谢谢”来引起人们的注意,并让人们对这些过程的美丽感兴趣。
Sustainability Awareness Posters
Tabitha Wall/新锐组




3
AOI会员奖
Days Spent in Isolation
Jason Chuang Art
新锐组 / 探索





在新冠肺炎的影响下,作者在室内度过了不同寻常的大量时间,他用这些时间来自我反思,探索如何通过各种视觉隐喻来传达自己的经历。在这段奇怪的时间里,解放思想,将情绪从身体中释放出来,这即是一种沉思,也是一种治愈。
4
《插画目录》奖
Personal exploration
Iris de Luz
专业组 / 探索



5
推荐奖
类目一:广告
Lockdown Cat Series
Myriam Wares/专业组





New Millennium stop motion
music video animation
Cecilia Abeid/新锐组

类目二:另类读物
Body and Soul
Antonio Sortino/专业组

Wildlife
Daniela Sosa/新锐组





类目三:书籍封面
The Deptford Trilogy
Karolis Strautniekas/专业组



Macbeth
Gaptoof/新锐组

类目四:儿童出版物
It isn't Rude to be Nude
Rosie Haine/专业组


Meat Thief
Chia-Ni Wu/新锐组

类目五:商业出版
Stories for Book Lovers
Natalia Zaratiegui/专业组





"The Outsider" by Albert Camus
Pavlena Mateeva/新锐组




类目六:编辑类插画
Karolis Strautniekas
Karolis Strautniekas/专业组

Contagion Fables
Karolis Strautniekas/新锐组



类目七:产品设计及包装
Biotherm limited edition
Carlos Arrojo/专业组

类目八:探索
Wine Time (Corona)
Nina Bachmann/专业组




类目九:科学
Lise Meitner Project
Elena Resko/专业组


What's In Us
Wenjing Yang/新锐组

6
创新奖
Typographic Bacteria
Xavier Segers
专业组 / 科技

7
SAA奖
Silk Road Wonders
Grace Park
新锐组 / 产品设计与包装














艺考用户说说
友善是交流的起点